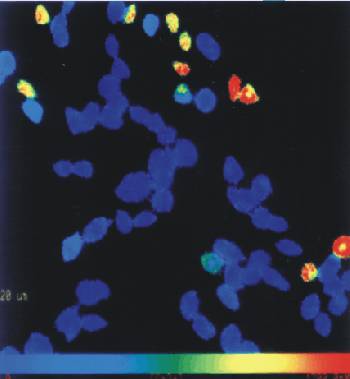

| IX: Der Rechner als Mitarbeiter (INHALT) |
 |
|
Digitale Bildverarbeitung (Einführung) Einige Beispiele Kombination von Bildern |
Mehr zum Thema Ca2+-Imaging im Vorlesungsteil "Fluoreszenztechniken II" LOWRES (29 kbyte) |
|
Die intrazelluläre Ca2+-Konzentration kann mit Hilfe Ca2+-empfindlicher Fluoreszenzfarbstoffe gemessen werden. Nach Registrierung der Fluoreszenz mit einer empfindlichen Kamera wird für jeden Bildpunkt die lokale Ca2+-Konzentration berechnet. Darauf wird jedem Wert der intrazellulären Ca2+-Konzentration eine Farbe zugeordnet. Niedrige Konzentrationen werden mit "kalten" Farben (blau, grün), höhere mit "warmen" Farbtönen (gelb, rot) dargestellt. Diese Falschfarbendarstellung erleichtert die optische Wahrnehmung kleiner Unterschiede im Meßsignal. |

|
| Der Vorteil von Falschfarbendarstellungen | |
|---|---|

|
|
| Hier ist dargestellt, wie einige Zellen auf einen Stimulus mit einem Anstieg der intrazellulären Ca2+-Konzentration reagieren. Die Kodierung der Ca2+-Konzentration entspricht dem oben gezeigten Spektrum. In der schwarz-weiß- Abbildung (links) sind Unterschiede zwischen den reagierenden Zellen nur schwer zu erkennen, und nicht-reagierende Zellen sind unsichtbar. Das Falschfarbenbild (rechts) zeigt deutlich Unterschiede zwischen den reagierenden Zellen und auch Unterschiede zwischen verschiedenen Bereichen einer Zelle. Die nicht-regierenden Zellen sind gut zu sehen. |
|
Bildfolgen von Falschfarbendarstellungen zeigen den Anstieg der Ca2+-Konzentration über einen Zeitraum hinweg (hier 50 s). Hier: HEK293-Zellen während der Aktivierung cGMP-gesteuerter, Ca2+-permeabler Ionenkanäle. |

|